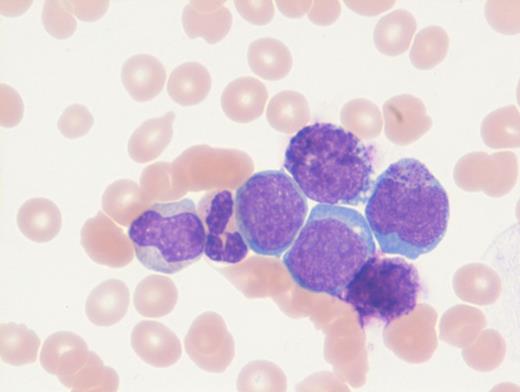

A previously healthy 27-year-old man presented to an outside hospital with bilateral ear aches and prescribed a short course of antibiotics with a working diagnosis of bilateral otitis media. Two weeks later, he presented to an outside hospital emergency department with syncope and was transferred immediately to our hospital for further care. During admission, on physical examination the patient was noted to have palpable splenomegaly. Laboratory tests performed were notable for a white blood cell count of 103.9 × 103/μL, hemoglobin of 8.1 g/dL, and platelets of 99 × 103/μL. Abnormal circulating cells were present in significant numbers (45%, black arrow; 12%, grey arrow). However, reverse transcriptase–polymerase chain reaction for BCR-ABL detected only very low numbers of both p210 and p190 transcripts. The images shown here are of a Giemsa-stained peripheral blood smear (Figure 1 [low power] and Figure 2 [high power]), hematoxylin and eosin stained bone marrow core biopsy (Figure 3), and CD61 immunostain on core biopsy for megakaryocytes (Figure 4).
A. Chronic myeloid leukemia in blast phase
B. Chronic myelomonocytic leukemia
C. Mast cell neoplasm consistent with Mast-cell leukemia
D. Ph+ acute myeloid leukemia
Sorry, that was not the preferred response.
Correct!
Chronic myelogenous leukemia (CML) in blast phase is defined by having 20 percent or more blasts in the peripheral blood or bone marrow or the finding of extramedullary blasts. However, this case in particular does not have the characteristic blast count, but rather the combination of findings including anemia, thrombocytopenia, marked basophilia, an additional Ph copy in conjunction with circulating blasts, and large focal clusters of medullary blasts that is consistent with blast phase. It has been suggested that blasts occupying an entire trabecular space or more, as seen in this case, can be considered presumptive evidence of blast phase even if the remaining marrow shows chronic phase.1 The CD61 immunostain highlights dwarf forms of megakaryocytes consistent with the CML diagnosis. Prominent fibrosis in this case resulted in a dry tap precluding an effective blast count, and CD34 immunostain was largely negative indicating a CD34-negative blast transformation. About 5 percent of cases present in accelerated or blast phase without a preceding chronic phase.
Fluorescence in situ hybridization (FISH) and karyotype findings in this case showed and additional Ph copy by cytogenetics, as well as to the presence of a t(9;22) in all cells examined by FISH analysis. Other chromosomal abnormalities (ACAs) in CML include trisomy 8, an extra Ph chromosome, i(17)(q10), and trisomy 19. This patient had both trisomy 8 and +19. Approximately 30 percent of cases in accelerated phase and 80 to 90 percent of cases in blast phase have ACAs.2
Molecular findings unique in this case were the low level of BCR-ABL transcripts likely related to the poor binding of primer sets due to mutations occurring at the primer binding site due to the additional complex cytogenetic abnormalities. Rarely, p210 and p190 transcripts can be seen together in CML. The hallmark of CML is expression of p210 mRNA; however, coexpression of p190 is not uncommon and is due to alternative splicing of the BCR gene. No BCR-ABL kinase mutations were identified in this case.
Option B is incorrect because chronic myelomonocytic leukemia is defined by having persistent peripheral blood monocytosis (≥1 × 103/μL) with monocytes accounting for ≥10 percent or more of the differential and the absence of RT-PCR BCR-ABL transcripts. Option C is incorrect. Circulating abnormal granulated cells in the blood smear are basophils and not mast cells. Also, the presence of any p210 and p190 transcripts would be inconsistent with MCL. Option D is a rare diagnosis (currently a provisional entity in the current WHO 2017 classification) characterized by leukocytosis with a blast predominance, anemia, and thrombocytopenia. However, in comparison to CML in blast phase, patients with Ph+ AML have less frequent splenomegaly and lower peripheral blood basophilia (<2%).
References
References
Dr. Parker indicated no relevant conflicts of interest.